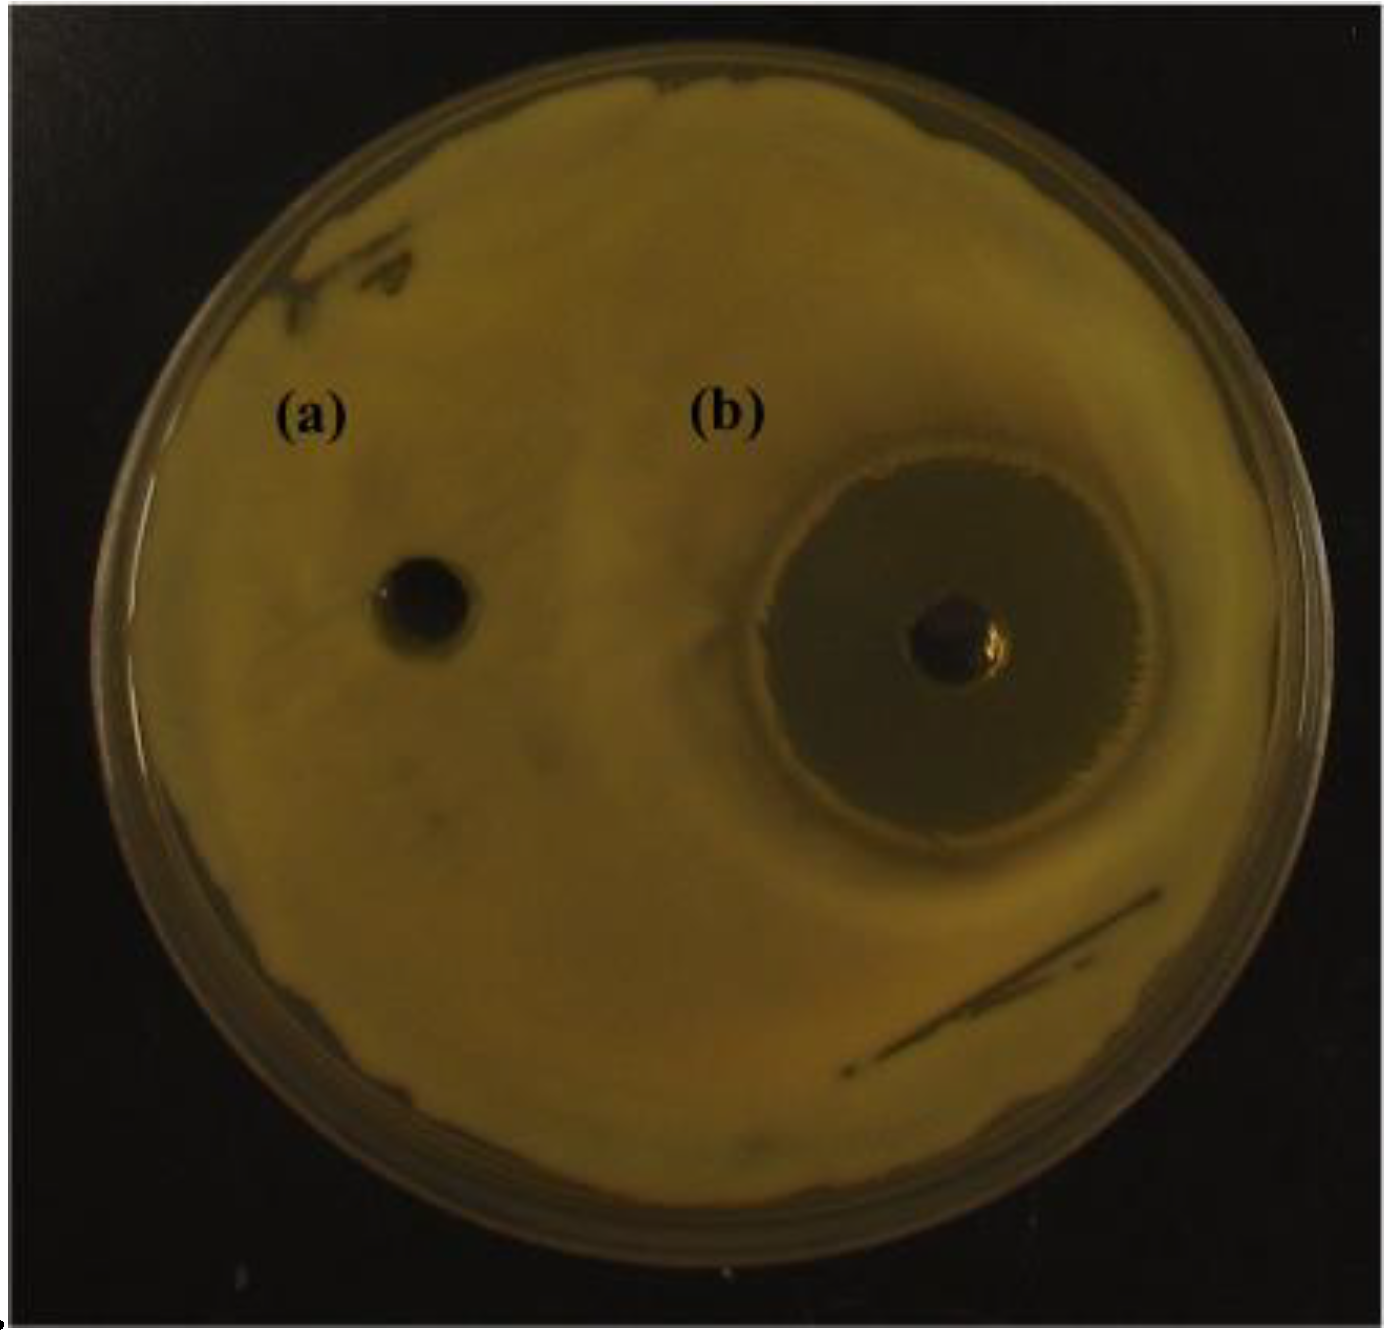
Applmicrobiol 01 00006 g001 Applmicrobiol 01 00006 g001

Pseudomonas entomophila 23S Produces a Novel Antagonistic Compound against Clavibacter michiganensis subsp. michiganensis, a Pathogen of Tomato Bacterial Canker
Abstract
1. Introduction
2. Materials and Methods
2.1. Bacterial Growth Conditions
2.2. Butanol Extraction of Bacterial Culture
2.3. Agar Well Diffusion Assay
2.4. Solid-Phase Extraction (SPE)
2.5. Comparisons of SPE Fractions from Different Strains
2.6. LC-HRMS/MS Analysis
2.7. HPLC Semi-Preparative Purification
2.8. LC-UV-MS Analysis of HPLC Purified Fractions
2.9. NMR Characterization of HPLC Fraction 1
2.10. Effects of Media on Anti-Cmm Activity of Butanol Extracts
2.11. Effects of the Two Purified Anti-CMM Compounds on Cmm Growth Curves
3. Results
3.1. Anti-Cmm Activity of Butanol Extract and Anti-Cmm Activity of Solid-Phase Extraction (SPE) Fractions
3.2. LC-MS Analysis of SPE Fractions from Two Strains of Pseudomonas
3.3. Effects of Different Media on Anti-Cmm Activity of Butanol Extracts
3.4. Effects of Two Purified Anti-Cmm Compounds on Cmm Growth Curve
4. Discussion
Supplementary Materials
Author Contributions
Funding
Institutional Review Board Statement
Informed Consent Statement
Data Availability Statement
Conflicts of Interest
References
- Agrio, G.N. Plant Pathology; Academic Press: London, UK, 2005. [Google Scholar]
 - Gillor, O.; Ghazaryan, L. Recent advances in bacteriocin application as antimicrobials. Recent Pat. Antiinfect. Drug Discov. 2007, 2, 115–122. [Google Scholar] [CrossRef]
 - Mnif, I.; Ghribi, D. Potential of bacterial derived biopesticides in pest management. Crop Prot. 2015, 77, 52–64. [Google Scholar] [CrossRef]
 - Strobel, G.; Daisy, B.; Castillo, U.; Harper, J. Natural products from endophytic microorganisms. J. Nat. Prod. 2004, 67, 257–268. [Google Scholar] [CrossRef]
 - Ojiambo, P.S.; Scherm, H. Biological and application-oriented factors influencing plant disease suppression by biological control: A meta-analytical review. Phytopathology 2006, 96, 1168–1174. [Google Scholar] [CrossRef]
 - Wang, X.Y.; Xu, Y.Q.; Lin, S.J.; Liu, Z.Z.; Zhong, J.J. Novel antiphytopathogenic compound 2-heptyl-5-hexylfuran-3-carboxylic acid, produced by newly isolated Pseudomonas sp. strain SJT25. Appl. Environ. Microbiol. 2011, 77, 6253–6257. [Google Scholar] [CrossRef] [PubMed]
 - Whipps, J.M. Developments in the biological control of soil-borne plant pathogens. Adv. Bot. Res. 1997, 26, 1–134. [Google Scholar]
 - Raaijmakers, J.M.; De Bruijn, I.; Nybroe, O.; Ongena, M. Natural functions of lipopeptides from Bacillus and Pseudomonas: More than surfactants and antibiotics. FEMS Microbiol. Rev. 2010, 34, 1037–1062. [Google Scholar] [CrossRef]
 - Haas, D.; Keel, C. Regulation of antibiotic production in root-colonizing Pseudomonas sp. and relevance for biological control of plant disease. Annu. Rev. Phytopathol. 2003, 41, 117–153. [Google Scholar] [CrossRef] [PubMed]
 - Santoyo, G.; Orozco-Mosqueda, M.D.C.; Govindappa, M. Mechanisms of biocontrol and plant growth-promoting activity in soil bacterial species of Bacillus and Pseudomonas: A review. Biocontrol Sci. Technol. 2012, 22, 855–872. [Google Scholar] [CrossRef]
 - Takishita, Y.; Charron, J.B.; Smith, D.L. Biocontrol rhizobacterium Pseudomonas sp. 23S induces systemic resistance in tomato (Solanum lycopersicum L.) against bacterial canker Clavibacter michiganensis subsp. michiganensis. Front. Microb. 2018, 9, 2119. [Google Scholar] [CrossRef]
 - Gleason, M.L.; Gitaitis, R.D.; Ricker, M.D. Recent progress in understanding and controlling bacterial canker of tomato in eastern North America. Plant Dis. 1993, 77, 1069–1076. [Google Scholar] [CrossRef]
 - de León, L.; Siverio, F.; López, M.M.; Rodríguez, A. Clavibacter michiganensis subsp. michiganensis, a Seedborne Tomato Pathogen: Healthy Seeds Are Still the Goal. Plant Dis. 2011, 95, 1328–1338. [Google Scholar]
 - Carlton, W.M.; Braun, E.J.; Gleason, M.L. Ingress of Clavibacter michiganensis subsp. michiganensis into tomato leaves through hydathodes. Phytopathology 1998, 88, 525–529. [Google Scholar] [PubMed]
 - Gartemann, K.H.; Kirchner, O.; Engemann, J.; Gräfen, I.; Eichenlaub, R.; Burger, A. Clavibacter michiganensis subsp. michiganensis: First steps in the understanding of virulence of a Gram-positive phytopathogenic bacterium. J. Biotechnol. 2003, 106, 179–191. [Google Scholar]
 - Sharabani, G.; Manulis-Sasson, S.; Borenstein, M.; Shulhani, R.; Lofthouse, M.; Chalupowicz, L.; Shtienberg, D. The significance of guttation in the secondary spread of Clavibacter michiganensis subsp. michiganensis in tomato greenhouses. Plant Pathol. 2013, 62, 578–586. [Google Scholar]
 - Fatmi, M.; Schaad, N.W.; Bolkan, H.A. Seed treatments for eradicating Clavibacter michiganensis subsp. michiganensis from naturally infected tomato seeds. Plant Dis. 1991, 75, 383–385. [Google Scholar]
 - Chang, R.J.; Ries, S.M.; Pataky, J.K. Local sources of Clavibacter michiganensis subsp. michiganensis in the development of bacterial canker on tomatoes. Phytopathology 1992, 82, 553–560. [Google Scholar]
 - Kawaguchi, A.; Tanina, K. Genetic groups of Clavibacter michiganensis subsp. michiganensis identified by DNA fingerprinting and the effects of inoculation methods on disease development. Eur. J. Plant Pathol. 2014, 140, 399–406. [Google Scholar]
 - Xu, X.; Kumar, A.; Deblais, L.; Pina-Mimbela, R.; Nislow, C.; Fuchs, J.R.; Miller, S.A.; Rajashekara, G. Discovery of novel small molecule modulators of Clavibacter michiganensis subsp. michiganensis. Front. Microbial. 2015, 6, 112. [Google Scholar]
 - Hausbeck, M.K.; Bell, J.; Medina-Mora, C.; Podolsky, R.; Fulbright, D.W. Effect of bactericides on population sizes and spread of Clavibacter michiganensis subsp. michiganensis on tomatoes in the greenhouse and on disease development and crop yield in the field. Phytopathology 2000, 90, 38–44. [Google Scholar]
 - Amkraz, N.; Boudyach, E.H.; Boubaker, H.; Bouizgarne, B.; Aoumar, A.A.B. Screening for fluorescent pseudomonades, isolated from the rhizosphere of tomato, for antagonistic activity toward Clavibacter michiganensis subsp. michiganensis. World J. Microbiol. Biotechnol. 2010, 26, 1059–1065. [Google Scholar] [CrossRef]
 - Lanteigne, C.; Gadkar, V.J.; Wallon, T.; Novinscak, A.; Filion, M. Production of DAPG and HCN by Pseudomonas sp. LBUM300 contributes to the biological control of bacterial canker of tomato. Phytopathology 2012, 102, 967–973. [Google Scholar] [CrossRef]
 - Aksoy, H.M.; Kaya, Y.; Ozturk, M.; Secgin, Z.; Onder, H.; Okumus, A. Pseudomonas putida–Induced response in phenolic profile of tomato seedlings (Solanum lycopersicum L.) infected by Clavibacter michiganensis subsp. michiganensis. Biol. Control. 2017, 105, 6–12. [Google Scholar] [CrossRef]
 - Barda, O.; Shalev, O.; Alster, S.; Buxdorf, K.; Gafni, A.; Levy, M. Pseudozyma aphidis induces salicylic-acid-independent resistance to Clavibacter michiganensis in tomato plants. Plant Dis. 2015, 99, 621–626. [Google Scholar] [PubMed]
 - Kotan, R.; Dadasoğlu, F.; Karagoz, K.; Cakir, A.; Ozer, H.; Kordali, S.; Cakmakci, R.; Dikbas, N. Antibacterial activity of the essential oil and extracts of Satureja hortensis against plant pathogenic bacteria and their potential use as seed disinfectants. Sci. Hortic. 2013, 153, 34–41. [Google Scholar] [CrossRef]
 - Özdemir, Z.; Erincik, Ö. Antimicrobial activities of extracts of Cyperus rotundus L. rhizomes against some bacterial and fungal pathogens of strawberry and tomato. Arch. Phytopathol. Plant Protect. 2015, 48, 850–861. [Google Scholar]
 - Li, S.; Jin, X.; Chen, J.; Lu, S. Inhibitory activities of venom alkaloids of Red Imported Fire Ant against Clavibacter michiganensis subsp. michiganensis in vitro and the application of piperidine alkaloids to manage symptom development of bacterial canker on tomato in the greenhouse. Int. J. Pest Manag. 2013, 59, 150–156. [Google Scholar]
 - Choi, J.; Baek, K.H.; Moon, E. Antimicrobial Effects of a Hexapetide KCM21 against Pseudomonas syringae pv. tomato DC3000 and Clavibacter michiganensis subsp. michiganensis. Plant Pathol. J. 2014, 30, 24. [Google Scholar]
 - Souleimanov, A.; Prithiviraj, B.; Smith, D.L. The major Nod factor of Bradyrhizobium japonicum promotes early growth of soybean and corn. J. Exp. Bot. 2002, 53, 1929–1934. [Google Scholar] [CrossRef] [PubMed]
 - Pitkin, D.H.; Martin-Mazuelos, E. Bioassay Methods for Antimicrobial and Antifungal Agents. In Antimicrobial Susceptibility Testing Protocols; CRC Press: Boca Raton, FL, USA, 2007; p. 313. [Google Scholar]
 - Wiegand, I.; Hilpert, K.; Hancock, R.E. Agar and broth dilution methods to determine the minimal inhibitory concentration (MIC) of antimicrobial substances. Nat. Protoc. 2008, 3, 163–175. [Google Scholar] [CrossRef]
 - Ricci, E.C. Investigating the Role of Pseudomonas sp. and Bacillus sp. Biofilms as Plant Growth Promoting Inoculants. Master’s Thesis, McGill University, Montreal, QC, Canada, December 2015. [Google Scholar]
 - Qing, Z.X.; Yang, P.; Tang, Q.; Cheng, P.; Liu, X.B.; Zheng, Y.J.; Liu, Y.S.; Zeng, J.G. Isoquinoline alkaloids and their antiviral, antibacterial, and antifungal activities and structure-activity relationship. Curr. Org. Chem. 2017, 21, 1920–1934. [Google Scholar] [CrossRef]
 - Sato, F.; Kumagai, H. Microbial production of isoquinoline alkaloids as plant secondary metabolites based on metabolic engineering research. Proc. Jpn. Acad. Ser. B 2013, 89, 165–182. [Google Scholar] [CrossRef] [PubMed][Green Version]
 - Baccile, J.A.; Spraker, J.E.; Le, H.H.; Brandenburger, E.; Gomez, C.; Bok, J.W.; Macheleidt, J.; Brakhage, A.A.; Hoffmeister, D.; Keller, N.P.; et al. Plant-like biosynthesis of isoquinoline alkaloids in Aspergillus fumigatus. Nat. Chem. Biol. 2016, 12, 419–424. [Google Scholar] [CrossRef]
 - Nord, C.; Levenfors, J.J.; Bjerketorp, J.; Sahlberg, C.; Guss, B.; Öberg, B.; Broberg, A. Antibacterial Isoquinoline Alkaloids from the Fungus Penicillium Spathulatum Em19. Molecules 2019, 24, 4616. [Google Scholar]
 - Solecka, J.; Zajko, J.; Postek, M.; Rajnisz, A. Biologically active secondary metabolites from Actinomycetes. Open Life Sci. 2012, 7, 373–390. [Google Scholar] [CrossRef]
 - Zhao, Z.M.; Shang, X.F.; Lawoe, R.K.; Liu, Y.Q.; Zhou, R.; Sun, Y.; Yan, Y.F.; Li, J.C.; Yang, G.Z.; Yang, C.J. Anti-phytopathogenic activity and the possible mechanisms of action of isoquinoline alkaloid sanguinarine. Pestic. Biochem. Physiol. 2019, 159, 51–58. [Google Scholar] [CrossRef] [PubMed]
 - Zaki, R.M.; Kamal El-Dean, A.M.; Radwan, S.M.; Sayed, S.M. Synthesis and Antimicrobial Activity of Novel Piperidinyl Tetrahydrothieno [2, 3-c] isoquinolines and Related Heterocycles. ACS Omega 2019, 5, 252–264. [Google Scholar] [CrossRef]
 - Galán, A.; Moreno, L.; Párraga, J.; Serrano, Á.; Sanz, M.J.; Cortes, D.; Cabedo, N. Novel isoquinoline derivatives as antimicrobial agents. Bioorg. Med. Chem. 2013, 21, 3221–3230. [Google Scholar]
 - Zielińska, S.; Wójciak-Kosior, M.; Dziągwa-Becker, M.; Gleńsk, M.; Sowa, I.; Fijałkowski, K.; Rurańska-Smutnicka, D.; Matkowski, A.; Junka, A. The Activity of Isoquinoline Alkaloids and Extracts from Chelidonium majus against Pathogenic Bacteria and Candida sp. Toxins 2019, 11, 406. [Google Scholar] [CrossRef]
 - Cushnie, T.T.; Cushnie, B.; Lamb, A.J. Alkaloids: An overview of their antibacterial, antibiotic-enhancing and antivirulence activities. Int. J. Antimicrob. Agents 2014, 44, 377–386. [Google Scholar]
 - Diamond, A.; Desgagné-Penix, I. Metabolic engineering for the production of plant isoquinoline alkaloids. Plant Biotechnol. J. 2016, 14, 1319–1328. [Google Scholar] [CrossRef] [PubMed]
 - Vining, L.C. Functions of secondary metabolites. Annu. Rev. Microbiol. 1990, 44, 395–427. [Google Scholar] [CrossRef] [PubMed]

| % Acetonitrile (in Fractions)  | Zone of Inhibition  (mm)  | 
|---|---|
| 10–40% | n/a | 
| 50 | 4 | 
| 60 | 20 | 
| 70 | 14 | 
| 80 | 11 | 
| m/z | m/z Calculated  | Ion Formula  | ppm | Neutral Loss | 
|---|---|---|---|---|
| 57.0697 | 57.0699 | C4H9+ | −3.9 | C11H8N2O | 
| 85.0640 | 85.0648 | C5H9O+ | −9.0 | C10H8N2 | 
| 130.0649 | 130.0651 | C9H8N+ | −1.9 | C6H9NO | 
| 142.0644 | 142.0651 | C10H8N+ | −5.0 | C5H9NO | 
| 157.0758 | 157.0760 | C10H9N2+ | −1.4 | C5H8O | 
| 198.0788 | 198.0788 | C12H10N2O+ * | −0.3 | C3H7 * | 
| 241.1341 | 241.1335 | C15H17N2O+ | 2.4 | 
| m/z | m/z Calculated  | Ion Formula  | ppm | Neutral Loss | 
|---|---|---|---|---|
| 71.0853 | 71.0855 | C5H11+ | −3.0 | C11H8N2O | 
| 99.0799 | 99.0804 | C6H11O+ | −5.3 | C10H8N2 | 
| 130.0651 | 130.0651 | C9H8N+ | −0.3 | C7H11NO | 
| 142.0649 | 142.0651 | C10H8N+ | −1.3 | C6H11NO | 
| 157.0761 | 157.0760 | C10H9N2+ | 0.3 | C6H10O | 
| 198.0782 | 198.0788 | C12H10N2O+ * | −2.8 | C4H9 * | 
| 255.1499 | 255.1492 | C16H19N2O+ | 2.9 | 
Publisher’s Note: MDPI stays neutral with regard to jurisdictional claims in published maps and institutional affiliations.  | 
© 2021 by the authors. Licensee MDPI, Basel, Switzerland. This article is an open access article distributed under the terms and conditions of the Creative Commons Attribution (CC BY) license (https://creativecommons.org/licenses/by/4.0/).
Share and Cite
Takishita, Y.; Souleimanov, A.; Bourguet, C.; Ohlund, L.B.; Arnold, A.A.; Sleno, L.; Smith, D.L. Pseudomonas entomophila 23S Produces a Novel Antagonistic Compound against Clavibacter michiganensis subsp. michiganensis, a Pathogen of Tomato Bacterial Canker. Appl. Microbiol. 2021, 1, 60-73. https://doi.org/10.3390/applmicrobiol1010006
Takishita Y, Souleimanov A, Bourguet C, Ohlund LB, Arnold AA, Sleno L, Smith DL. Pseudomonas entomophila 23S Produces a Novel Antagonistic Compound against Clavibacter michiganensis subsp. michiganensis, a Pathogen of Tomato Bacterial Canker. Applied Microbiology. 2021; 1(1):60-73. https://doi.org/10.3390/applmicrobiol1010006
Chicago/Turabian StyleTakishita, Yoko, Alfred Souleimanov, Carine Bourguet, Leanne B. Ohlund, Alexandre A. Arnold, Lekha Sleno, and Donald L. Smith. 2021. "Pseudomonas entomophila 23S Produces a Novel Antagonistic Compound against Clavibacter michiganensis subsp. michiganensis, a Pathogen of Tomato Bacterial Canker" Applied Microbiology 1, no. 1: 60-73. https://doi.org/10.3390/applmicrobiol1010006
APA StyleTakishita, Y., Souleimanov, A., Bourguet, C., Ohlund, L. B., Arnold, A. A., Sleno, L., & Smith, D. L. (2021). Pseudomonas entomophila 23S Produces a Novel Antagonistic Compound against Clavibacter michiganensis subsp. michiganensis, a Pathogen of Tomato Bacterial Canker. Applied Microbiology, 1(1), 60-73. https://doi.org/10.3390/applmicrobiol1010006
        
